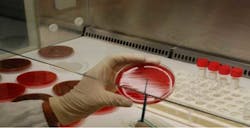
Microorg3 Fo Microorg3 Fo

Introduction of hygienists in a long-term care facility for patients with Alzheimer's disease, cognitive impairment
This poster was presented at Europerio 7 in Vienna Austria, June 6-9, 2012. The project aims were to: include the dental hygienist within the multidisciplinary team caring for patients with Alzheimer’s disease in order to establish a bridge and continuing collaboration between the teams and the Alzheimer’s Oral Health Service of the Department of Dentistry of Pio Albergo Trivulzio, through the development of a shared protocol in order to pursue the following objectives:
• Improve the appearance of care understood as a structure, staff, and family;
• Improve the quality of life of hospitalized patients;
• Reduce risks factor;
• Reduce acute and related chronic diseases.
This project's aims were to:
• Assess health status and oral hygiene in patients with Alzheimer’s disease or cognitive impairment patients in nursing homes, by insertion of a tool for evaluating the oral cavity (OHAT);
• Assess current knowledge and practices of oral hygiene of service personnel of departments, through questionnaires;
• Raise awareness and educate health workers and caregivers on appropriate strategies and products suitable for a proper oral hygiene through development of a basic protocol and direct training;
• Develop a custom protocol adapted to individual patient needs to be included in the integrated personnel folder;
• Plan and implement interventions aimed at restoring the dentistry of oral health;
• Determine indicators extensible for verification of results;
• Assess the perception of improvement of the assistance provided through the forms of satisfaction with the service, addressed to relatives and medical staff and health.
Figure 1 - Distribution of patients by age and gender
100% of patients suffering from various degrees of dementia with BPSD and: • 70% of patients suffering from heart disease and hypertension • 40% of patients are diabetic • 35% of patients suffering from COPD 100% of patients were considered as not independent in performing the necessary maneuvers of oral hygiene.Table 2 - Breakdown of patients according to the dental state
This suggests that: 51% of patients were fully edentulous; 51% of patients do not keep a proper masticatory function; 49% of patients retained adequate masticatory function.
According to the score obtained by the oral health assessment form (OHAT), we can separate patients in the following way: 92% of the patients presented moderate alterations of oral health; 8% of the patients have severe abnormalities of the oral health.